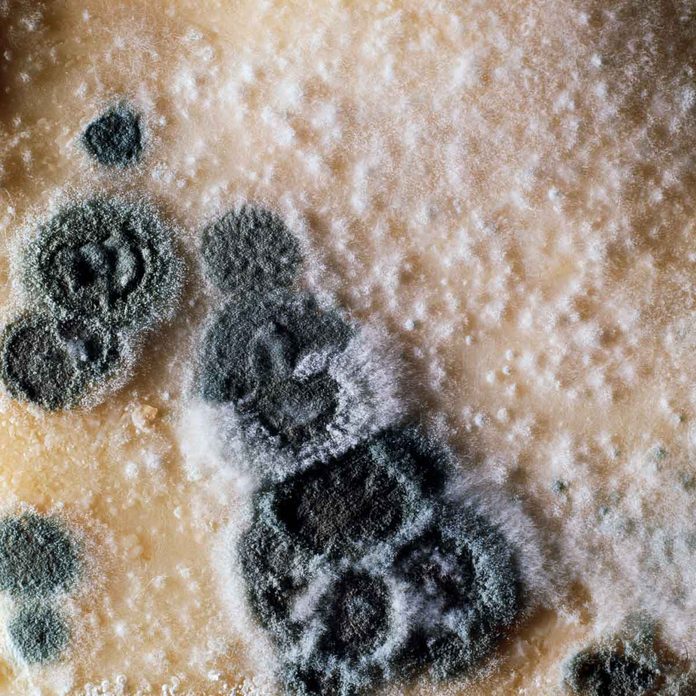
Penicillium mold

If you've got mold, determine what type of mold it is and then you can make a plan to get rid of it.
10 Common Molds Found in the Home

Understanding Types of Mold
Mold is a broad term that describes a range of micro-organisms that grow in the presence of a food source and usually require sufficient moisture. More specifically, mold is a type of fungi, and growths are sometimes generically called “mildew.” Mold usually falls into one of three broad categories.
Allergenic molds are not toxic in and of themselves, but can trigger allergic reactions such as asthma.
Pathogenic molds can trigger illnesses in people already weakened by other causes.
Toxigenic families of molds are the most dangerous because they create their own toxins that can lead to health problems that are sometimes lethal.
Fortunately, regardless of the type of mold you’ve got, it can be killed with a registered fungicide. (A registered fungicide has been tested by an independent government body and found to be effective and safe.) Find out what mold mites are and how to get rid of them.
Read on to learn more about the different types of molds and how to recognize them.

Chaetomium
Type of Mold: Allergenic.
Where It’s Found: Water-damaged homes.
Soil and plant debris is the natural outdoor habitat of this mold, but this mold on plant soil is also the most common mold to grow in houses damaged by flooding and large water leaks.
Chaetomium is an allergenic mold that often starts as a fuzzy white growth. Over time, it darkens and can sometimes look like the dreaded black mold. The two types can even grow in the same location. Sufficient moisture is necessary for the growth of both.

Stachybotrys (Black mold)
Type of Mold: Toxigenic.
Where It’s Found: Damp areas, including ventilation systems.
There are dozens of species of the toxigenic mold stachybotrys, but two in particular are noteworthy. Stachybotrys chartarum and stachybotrys chlorohalonata are also known as toxic black mold. These sometimes appear indoors or in ventilation systems.
Both species are associated with poor indoor air quality, typically stemming from too much moisture. Stachybotrys is also associated with sick building syndrome. This mold is dangerous enough that it should be removed only by licensed remediation specialists as part of a campaign to eliminate excess moisture.

Trichoderma
Type of Mold: Toxigenic.
Where It’s Found: Damp soil.
This common family of molds is found in soils around the world. There are 89 recognized species of this mold, with Trichoderma longibrachiatum, a.k.a. “common house mold,” one of the most prevalent.
It can grow anywhere in the home where organic matter and sufficient moisture are present. Trichoderma is considered a toxigenic mold because it produces mycotoxins under certain conditions. Some strains of Trichoderma go into anti-fungal treatments for plants.

Alternaria
Type of Mold: Allergenic.
Where It’s Found: Bathrooms and damp windows.
Got moldy stuff growing in your bathroom or shower? Perhaps mold along the bottom of windows where condensation develops during cold weather? It’s probably a mold called Alternaria. This is the most common type of allergenic mold.
From the genus ascomycete, this organism thrives around the globe outdoors in natural ecosystems. But Alternaria can cause problems when it ventures indoors. It causes allergic reactions in people, and can also trigger hypersensitive conditions such as hay fever and asthma. This organism can infect people whose immune systems are impeded.

Ulocladium
Type of Mold: Allergenic.
Where It’s Found: Damp appliances, bathrooms, drywall, carpet and more.
This common allergenic household mold is found in wet places such as showers, bath tubs or condensation-prone windows, as well as appliances like dish and clothes washers. Water-dispensing refrigerators with chronically leaking hose connections also may be vulnerable.
Ulocladium is black in color, and while it’s not as dangerous as the infamous “black mold,” the appearance of any mold is cause for concern and action. Ulocladium also grows on drywall and carpet and requires high levels of moisture to thrive.

Serpula
Type of Mold: Allergenic.
Where It’s Found: Wooden (and not always particularly damp) structures.
One species called Serpula lacrymans is rare in nature and feeds almost exclusively on wooden structures. It’s a mildly allergenic mold that does not pose much of a health hazard to people, although it is destructive.
If you see a house frame that’s dry all the time yet still crumbles to pieces, you’ve seen dry rot in action. The direct translation of the Latin name means “creeping” (serpula) and “making tears” (lacrymans) because of its ability to infect and destroy wooden structures without high levels of moisture.

Mucor
Type of Mold: Mostly allergenic (with one toxigenic exception).
Where It’s Found: Water-damaged structural materials, carpets and mattresses.
There are about 40 species of this fast-growing white or gray mold. Most are considered just allergenic. However, one species, Mucor indicus, is considered toxigenic because it can lead to fungal infection called zygomycosis, causing the death of living tissue.
Some species of Mucor can also infect blood in a condition called mucormycosis. Mucor grows quickly at room temperature or warmer, and can sometimes approach an inch in thickness. Mucor mecudo is one common species. It’s generically called “pin mold” because the vertical growths with small heads look like sewing pins.

Aspergillus
Type of Mold: Pathogenic.
Where It’s Found: In the air and HVAC systems, especially in water-damaged buildings.
Although some members of the Aspergillus genus are non-toxic, they can trigger allergic reactions, respiratory irritation, lung infections and asthma. Other examples from the genus Aspergillus are toxigenic and can produce aflotoxins — chemicals that can trigger the growth of cancer.
The spores of Aspergillus fumigatus are found everywhere in the air, and this species is considered pathogenic. It can cause lethal infections in people with compromised immune systems. As with several other families of molds, Aspergillus also includes at least one species that’s useful to humans. Aspergillus sojae is essential for making authentic soy sauce, miso and other fermented condiments.
Penicillium
Type of Mold: Allergenic.
Where It’s Found: Anyplace with moisture.
Although a species of this mold called Penicillium notatum was the original source of lifesaving antibiotics, you don’t want any kind of Penicillium growing in your house.
This genus has many species, is bluish green and has a smooth texture. It’s considered an allergenic mold. The airborne spores travel easily and can trigger asthma and heart inflammation. As with all molds, high moisture conditions trigger its growth.

Aureobasidium
Type of Mold: Allergenic.
Where It’s Found: Underneath wallpaper and paint.
This is a fast-growing, black, allergenic yeast-like organism that thrives in outdoor environments worldwide and indoor environments with sufficient moisture.
In homes, Aureobasidium is most commonly found underneath wallpaper and paint and can vary greatly in color. One species, Aureobasidium pullulans, is the most widely known and is sometimes used in biotech research. It’s also key to certain products that control plant diseases and aid in food storage.